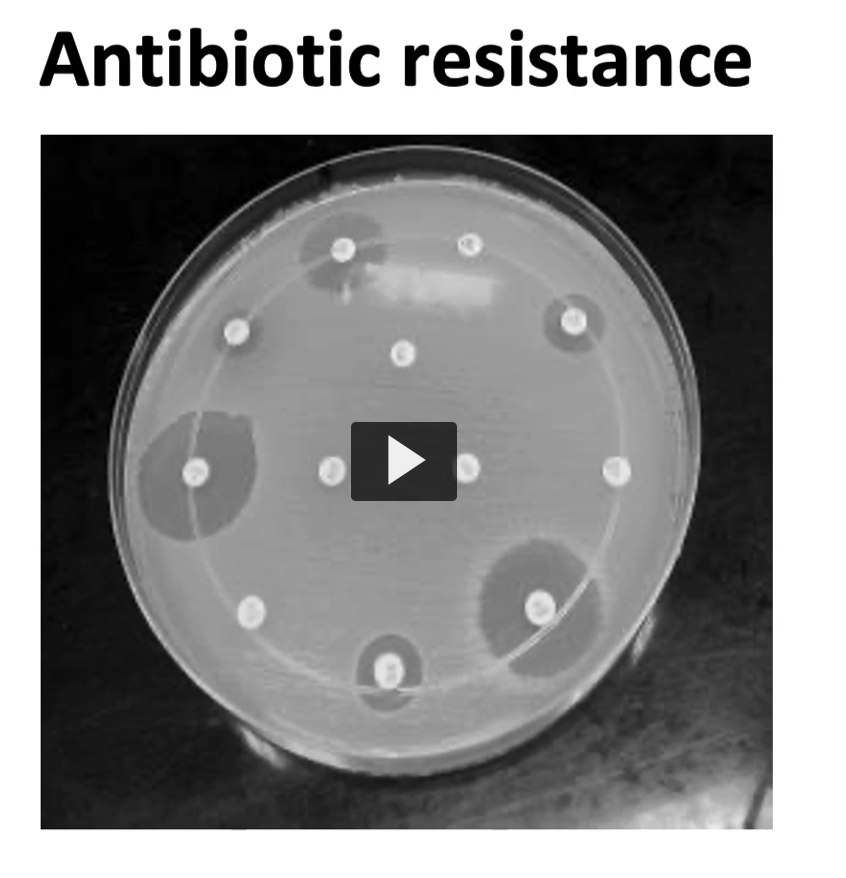
<p>come back to this</p>

1/27
Looks like no tags are added yet.
Name | Mastery | Learn | Test | Matching | Spaced | Call with Kai |
|---|
No analytics yet
Send a link to your students to track their progress



Biological role of genetic exchange in evolution
Genetic exchange and recombination work constantly to rearrange and modify chromosomes providing genetic diversity, the basis of evolution.
Genetic recombination constitute essential cellular processes that mediate DNA repair and gene expression regulation.
Biological role of genetic exchange in evolution
Genetic exchange between microorganism accelerates evolution by providing the donor cell with new genetic information instantly.
Transfer of genes allows recipient cell to rapidly acquire properties that make them more fit to withstand changing environmental conditions.
Genetic transfer is responsible for the rapid dissemination of multiple drug resistance (MDR) by Gram negative bacteria seen today.


When exogenous DNA enters the bacterial cytoplasm, it faces either degradation or stabilization by becoming a circular molecule.
IF it has a sequence known as an origin of replication, it can replicate independently.
It can also integrate within the chromosomal DNA via recombination and be passed onto the next generations.
DNA restriction and modification
Bacteria have evolved methods to protect their DNA from exogenous DNA:
Modification
attachment of protective groups to DNA
(e.g., methylation)
Restriction
degradation of unprotected DNA
Type — Activities — Comments
I
Endonucleases, methylases
Specific binding, non-specific cutting
II
Endonucleases only
Specific binding and cutting (cohesive ends)
III
Endonucleases, methylases
Specific binding, non-specific cutting

come back to this





















